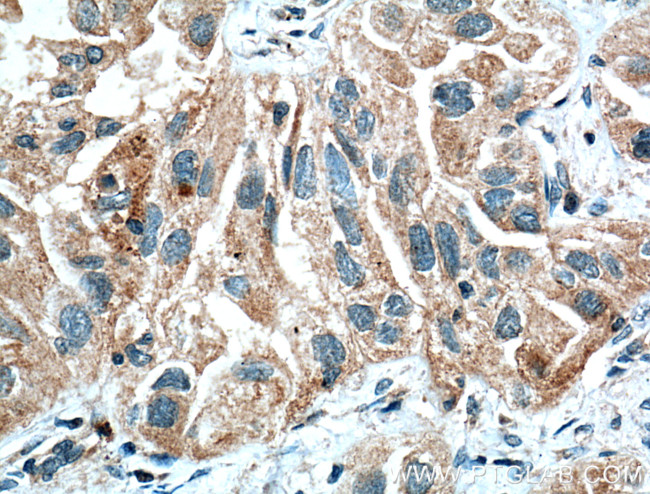
HIF1AN Antibody in Immunohistochemistry (Paraffin) (IHC (P))

Search
Proteintech
HIF1AN Polyclonal Antibody
{{$productOrderCtrl.translations['antibody.pdp.commerceCard.promotion.promotions']}}
{{$productOrderCtrl.translations['antibody.pdp.commerceCard.promotion.viewpromo']}}
{{$productOrderCtrl.translations['antibody.pdp.commerceCard.promotion.promocode']}}: {{promo.promoCode}} {{promo.promoTitle}} {{promo.promoDescription}}. {{$productOrderCtrl.translations['antibody.pdp.commerceCard.promotion.learnmore']}}




Please note: We are reviewing Western blot images included in the antibody testing data in our catalog, including those provided by third parties. Unless expressly labeled or annotated as “raw-unedited”, Western blot images included in the antibody testing data in our catalog may have been edited, optimized or otherwise adjusted for presentation.
产品信息
10646-1-AP
种属反应
宿主/亚型
分类
类型
抗原
偶联物
形式
浓度
规格
纯化类型
保存液
内含物
保存条件
运输条件
产品详细信息
Immunogen sequence: MAATAAEAV ASGSGEPREE AGALGPAWDE SQLRSYSFPT RPIPRLSQSD PRAEELIENE EPVVLTDTNL VYPALKWDLE YLQENIGNGD FSVYSASTHK FLYYDEKKMA NFQNFKPRSN REEMKFHEFV EKLQDIQQRG GEERLYLQQT LNDTVGRKIV MDFLGFNWNW INKQQGKRGW GQLTSNLLLI GMEGNVTPAH YDEQQNFFAQ IKGYKRCILF PPDQFECLYP YPVHHPCDRQ SQVDFDNPDY ERFPNFQNVV GYETVVGPGD VLYIPMYWWH HIESLLNGGI TITVNFWYKG APTPKRIEYP LKAHQKVAIM RNIEKMLGEA LGNPQEVGPL LNTMIKGRYN (1-349 aa encoded by BC007719)
靶标信息
Hydroxylates HIF-1 alpha at 'Asn-803' in the C-terminal transactivation domain (CAD). Functions as an oxygen sensor and, under normoxic conditions, the hydroxylation prevents interaction of HIF-1 with transcriptional coactivators including Cbp/p300-interacting transactivator. Involved in transcriptional repression through interaction with HIF1A, VHL and histone deacetylases. Hydroxylates specific Asn residues within ankyrin repeat domains (ARD) of NFKB1, NFKBIA, NOTCH1, ASB4, PPP1R12A and several other ARD-containing proteins. Also hydroxylates Asp and His residues within ARDs of ANK1 and TNKS2, respectively. Negatively regulates NOTCH1 activity, accelerating myogenic differentiation. Positively regulates ASB4 activity, promoting vascular differentiation. [UniProt]
仅用于科研。不用于诊断过程。未经明确授权不得转售。
生物信息学
蛋白别名: DKFZp762F1811; Factor inhibiting HIF-1; FIH 1; FIH-1; FLJ20615; FLJ22027; Hypoxia-inducible factor 1-alpha inhibitor; Hypoxia-inducible factor asparagine hydroxylase
基因别名: 2310046M24Rik; A830014H24Rik; FIH; FIH1; HIF1AN
UniProt ID: (Mouse) Q8BLR9
Entrez Gene ID: (Rat) 309434, (Mouse) 319594